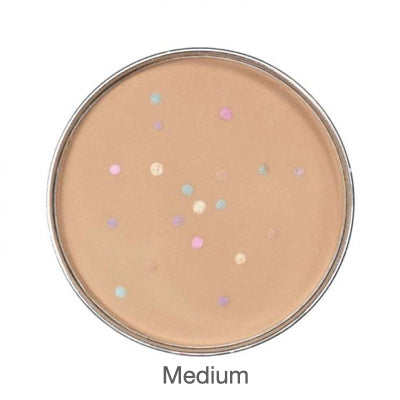

Find my shade

Have a question?
Notified by email when this product becomes available


Get the details
The Magic Minerals collection is your purse-sized secret to flawless skin with a lightweight, matte finish.
Easy to apply, the formulas cleverly adapt to match your own unique skin tone. The result is even, blemish-free skin and a youthful glow for all ages. Once in place, your makeup stays put for up to 12 hours without caking or creasing. Thanks to the super versatile, buildable coverage, Magic Minerals look stunning worn alone. Or layer them at the end of your regular routine to set, mattify, and perfect.
Like all our products, the Magic Minerals range contains Jerome’s special blend of skincare actives that care for your skin while you wear. Skin is protected, hydrated, plumped, and nourished while you get on with looking gorgeous.